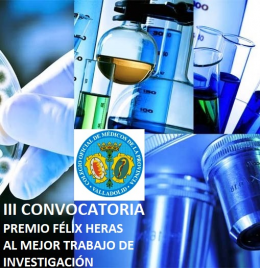

Finalizado el plazo de entrega de trabajos que optan al III Premio Félix Heras, al mejor artículo/trabajo de investigación publicado en los años 2018 y 2019, cuyo primer firmante sea un médico colegiado en Valladolid, se reunieron los miembros del tribunal el pasado día 17 de marzo a las 19.30 horas, en la sede de este colegio.
Se valoran 30 trabajos presentados dentro del plazo y que cumplían los requisitos exigidos en las bases de la convocatoria, con una altísima calidad científica e impacto internacional, y tras la oportuna deliberación y votación, el Jurado ha acordado conceder el III Premio Félix Heras dotado con 1.000 euros y Accésit de 500 €, ambos en categorías Junior y Senior a los siguientes trabajos de investigación:
CATEGORIA JUNIOR
Primer premio:
- “Observational, open-label, non-randomized study on the efficacy of onabotulinumtoxinA in the treatment of numular headache: The pre-numabot study”. Cephalalgia. 2019, Vol. 39 (14) 1818-1826. Del Dr. D. David García Azorín y colaboradores.
Accésit:
- “The Multivalvular Score for Predicting the Outcome of Mitral Regurgitation in Aortic Stenosis Patiens Treated With TAVI: Prospective Validation”. Del Dr. D. Pablo Catalá Ruiz y colaboradores.
CATEGORIA SENIOR
Primer premio:
- “Cumulative risks of stent migration and gastrointestinal bleeding in patients with lumen-apposing metal stents”. Endocscopy 2018; 49: 386-395. Del Dr. D. Francisco Javier García Alonso y colaboradores.
Accésit:
- “Tricuspid but not Mitral Regurgitation Determines Mortality After TAVI in Patiens With Nonsevere Mitral Regurgitation”. Rev. Esp. Cardiol. 2018; 71(5): 357-364. Del Dr. D. Ignacio J. Amat Santos y colaboradores.
El acto de entrega de dichos premios, así como la exposición pública del trabajo premiado, se realizará en la sede del Ilustre Colegio Oficial de Médicos de Valladolid, en fecha por determinar.